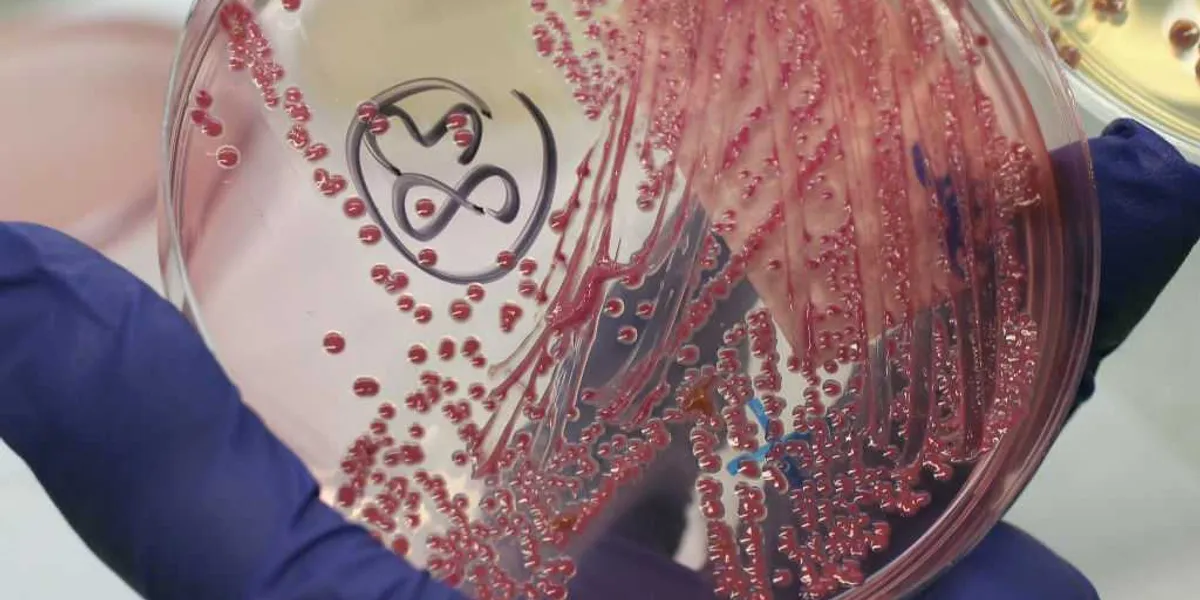
Another Chinese researcher busted for allegedly smuggling crop-harming biomaterial into America

TikTok Selling Block: Throw the Kids A Bone
.png) 2 hours ago
1
2 hours ago
1
Related
Bombshell Emails Expose Biden White House Involvement in Mar...
6 minutes ago
0
ICE is nice: Amfest attendees overwhelmingly call for DHS to...
6 minutes ago
0
Rubio identifies 'single most serious threat' to the US from...
8 minutes ago
0
Massie sets litmus test for DOJ's Epstein disclosures as dea...
21 minutes ago
0
Another Chinese researcher busted for allegedly smuggling cr...
22 minutes ago
0
Trending
Popular
They Are Globalizing the Intifada
4 days ago
60
R.I.P. Rob Reiner and His Wife Michelle Singer
4 days ago
34
© Presscanyon 2025. All rights are reserved

English (US)
English (US)